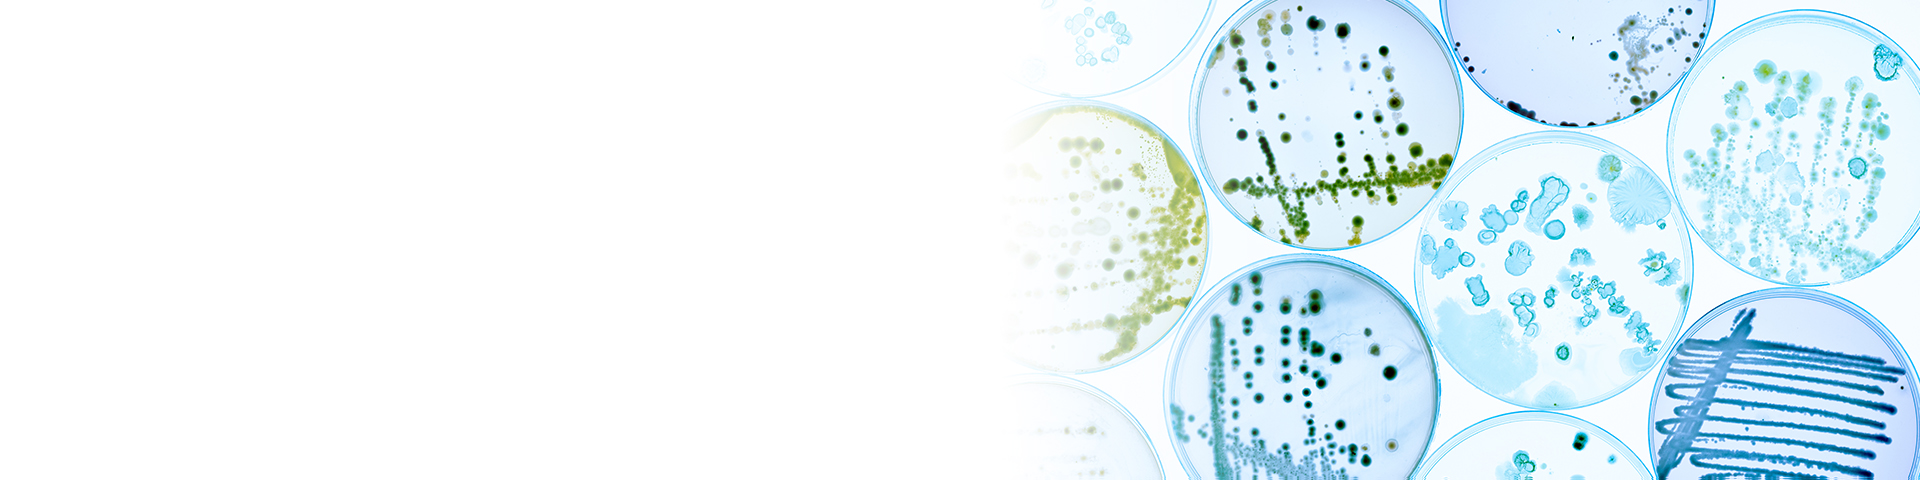

Laboratory Services

Pathology Laboratory
Through our partner laboratories, we deliver precise and research-driven diagnostic solutions. Our services span hematology, clinical chemistry, microbiology, histopathology, cytopathology, and molecular biology. Advanced diagnostics such as immunohistochemistry, immunology profiling, genetic testing, and molecular assays are powered by AI-enabled digital pathology platforms. Our partner laboratory operate under ISO 15189:2022, NABL accreditation, GLP compliance, and CAP-equivalent quality systems, ensuring accuracy, reliability, and regulatory readiness for both clinical and research applications.

Biomarkers in Clinical Research
We leverage biomarker expertise from our laboratory partners to translate biological signals into clinical meaning. Biomarkers support patient selection, measure therapeutic efficacy, and safeguard safety in trials. They help forecast outcomes, enable personalized medicine, and accelerate development timelines by acting as surrogate endpoints. This approach improves trial efficiency and strengthens evidence-based decision-making.

Biopsies in Clinical Research
Through specialized collaborations, we enable both clinical and research biopsy services. While clinical biopsies inform diagnosis and treatment, research biopsies provide deeper insights into disease pathways and drug mechanisms. Tissue analysis supports biomarker discovery and patient stratification. All procedures are conducted under strict ethical frameworks, with informed consent and compliance to FDA and international standards. Complementary innovations, including liquid biopsies, expand the possibilities for less invasive monitoring.
Microbiology
Our microbiology services, delivered through expert laboratory collaborations, provide comprehensive investigation of bacteria, viruses, fungi, and parasites. From conventional cultures to advanced molecular assays and MALDI-TOF mass spectrometry, we ensure precise and timely results. Resistance profiling, outbreak tracing, and surveillance programs strengthen antimicrobial stewardship and public health response. Advanced sequencing and bioinformatics tools further enhance microbial research and diagnostics.

Genome Sequencing
Through leading genomic laboratories, we provide access to state-of-the-art sequencing for rare disease diagnosis, oncology applications, reproductive and prenatal health, and predictive medicine. These services decode the genetic blueprint with speed and accuracy, enabling actionable insights that can be reinterpreted as science evolves. Ethical stewardship—including data privacy and informed consent—remains central in every collaboration.